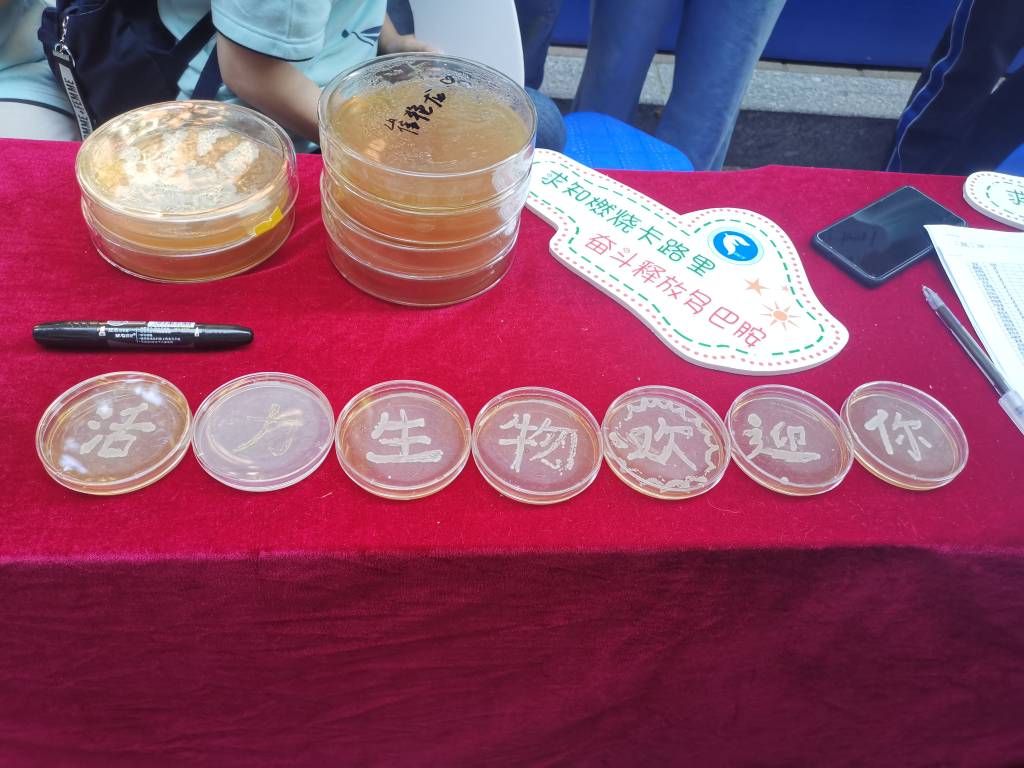

“列车到站请注意,凌工路2号到了,请前往大连理工大学的乘客携带好随身物品准备下车……”从五湖四海而来,相遇在凌水河畔。怀揣对未来的梦想与期待,背负着少年的骄傲和荣光,金秋九月,大工终于迎来了2020级新生。“萌新,你好!”“大工,我来啦!”
“列车到站请注意,凌工路2号到了,请前往大连理工大学的乘客携带好随身物品准备下车……”从五湖四海而来,相遇在凌水河畔。怀揣对未来的梦想与期待,背负着少年的骄傲和荣光,金秋九月,大工终于迎来了2020级新生。“萌新,你好!”“大工,我来啦!”
“列车到站请注意,凌工路2号到了,请前往大连理工大学的乘客携带好随身物品准备下车……”从五湖四海而来,相遇在凌水河畔。怀揣对未来的梦想与期待,背负着少年的骄傲和荣光,金秋九月,大工终于迎来了2020级新生。“萌新,你好!”“大工,我来啦!”
“列车到站请注意,凌工路2号到了,请前往大连理工大学的乘客携带好随身物品准备下车……”从五湖四海而来,相遇在凌水河畔。怀揣对未来的梦想与期待,背负着少年的骄傲和荣光,金秋九月,大工终于迎来了2020级新生。“萌新,你好!”“大工,我来啦!”
“列车到站请注意,凌工路2号到了,请前往大连理工大学的乘客携带好随身物品准备下车……”从五湖四海而来,相遇在凌水河畔。怀揣对未来的梦想与期待,背负着少年的骄傲和荣光,金秋九月,大工终于迎来了2020级新生。“萌新,你好!”“大工,我来啦!”
“列车到站请注意,凌工路2号到了,请前往大连理工大学的乘客携带好随身物品准备下车……”从五湖四海而来,相遇在凌水河畔。怀揣对未来的梦想与期待,背负着少年的骄傲和荣光,金秋九月,大工终于迎来了2020级新生。“萌新,你好!”“大工,我来啦!”
“列车到站请注意,凌工路2号到了,请前往大连理工大学的乘客携带好随身物品准备下车……”从五湖四海而来,相遇在凌水河畔。怀揣对未来的梦想与期待,背负着少年的骄傲和荣光,金秋九月,大工终于迎来了2020级新生。“萌新,你好!”“大工,我来啦!”
“列车到站请注意,凌工路2号到了,请前往大连理工大学的乘客携带好随身物品准备下车……”从五湖四海而来,相遇在凌水河畔。怀揣对未来的梦想与期待,背负着少年的骄傲和荣光,金秋九月,大工终于迎来了2020级新生。“萌新,你好!”“大工,我来啦!”
“列车到站请注意,凌工路2号到了,请前往大连理工大学的乘客携带好随身物品准备下车……”从五湖四海而来,相遇在凌水河畔。怀揣对未来的梦想与期待,背负着少年的骄傲和荣光,金秋九月,大工终于迎来了2020级新生。“萌新,你好!”“大工,我来啦!”
“列车到站请注意,凌工路2号到了,请前往大连理工大学的乘客携带好随身物品准备下车……”从五湖四海而来,相遇在凌水河畔。怀揣对未来的梦想与期待,背负着少年的骄傲和荣光,金秋九月,大工终于迎来了2020级新生。“萌新,你好!”“大工,我来啦!”
“列车到站请注意,凌工路2号到了,请前往大连理工大学的乘客携带好随身物品准备下车……”从五湖四海而来,相遇在凌水河畔。怀揣对未来的梦想与期待,背负着少年的骄傲和荣光,金秋九月,大工终于迎来了2020级新生。“萌新,你好!”“大工,我来啦!”
“列车到站请注意,凌工路2号到了,请前往大连理工大学的乘客携带好随身物品准备下车……”从五湖四海而来,相遇在凌水河畔。怀揣对未来的梦想与期待,背负着少年的骄傲和荣光,金秋九月,大工终于迎来了2020级新生。“萌新,你好!”“大工,我来啦!”